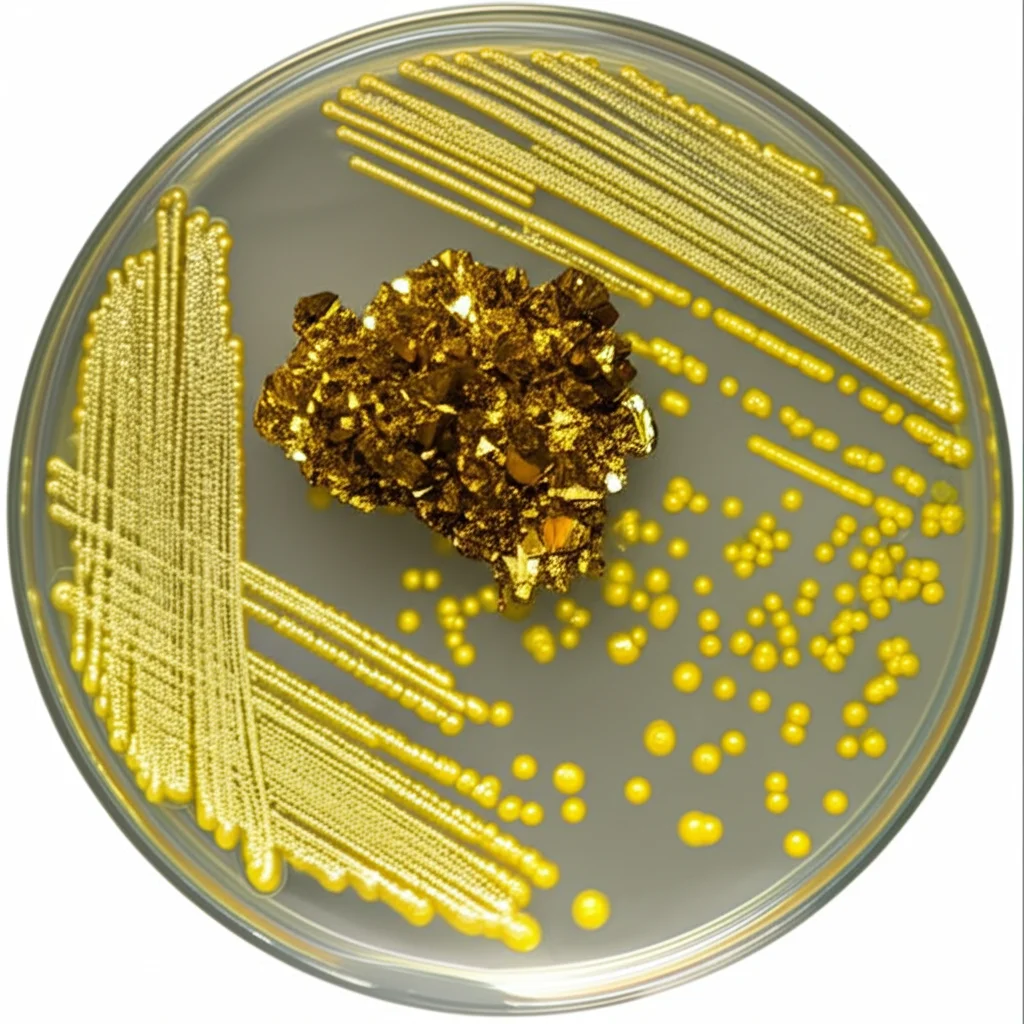
Macro lens, 100mm, high detail, controlled lighting, un piccolo campione di minerale monazite, ricco di terre rare, accanto a una piastra di Petri con colonie batteriche brillanti di Gluconobacter oxydans, simboleggiando il processo di bioleaching.

Batteri Minatori: La Rivoluzione Verde per Estrarre le Terre Rare!
Ciao a tutti! Oggi voglio parlarvi di qualcosa di veramente affascinante che sta succedendo nel mondo della scienza e della tecnologia sostenibile: l’uso di microrganismi, piccoli batteri operosi, per estrarre metalli preziosi chiamati terre rare. Sembra fantascienza, vero? Eppure, è una frontiera della ricerca che potrebbe rivoluzionare il modo in cui otteniamo materiali fondamentali per la nostra transizione energetica.
Perché le Terre Rare sono Così Importanti (e Problematiche)?
Partiamo dalle basi. Le Terre Rare (REE – Rare Earth Elements) non sono poi così “rare” in termini di abbondanza nella crosta terrestre, ma sono difficili da trovare concentrate in giacimenti economicamente sfruttabili e, soprattutto, la loro estrazione è un processo complesso e spesso molto inquinante. Pensate a neodimio, scandio, ittrio… nomi forse poco familiari, ma sono ingredienti essenziali per tecnologie che consideriamo ormai indispensabili:
- Magneti potentissimi per le turbine eoliche
- Motori efficienti per le auto elettriche
- Componenti cruciali per smartphone, computer e persino futuri superconduttori
La domanda di questi elementi sta esplodendo – si prevede che crescerà da 3 a 7 volte entro il 2040! Il problema? I metodi tradizionali di estrazione (idrometallurgia) usano acidi forti e producono scarti tossici, con un impatto ambientale notevole. Insomma, per costruire un futuro più verde, rischiamo di inquinare pesantemente nel presente. Un bel paradosso, no?
Entra in Scena il Bioleaching: La Natura ci Dà una Mano
Ed è qui che entriamo in gioco noi ricercatori, cercando alternative più “gentili” con il pianeta. Una delle strade più promettenti è il bioleaching, o biolisciviazione. In pratica, usiamo microrganismi capaci di “sciogliere” i metalli dalle rocce o dai materiali di scarto. Come? Producendo un cocktail di sostanze, chiamato biolisciviante, che agisce sui minerali.
Negli ultimi anni, un batterio in particolare si è distinto in questo campo: il Gluconobacter oxydans. È considerato sicuro (GRAS – Generally Regarded As Safe), è un campione nella produzione di acidi organici (soprattutto acido gluconico) e si è dimostrato efficace nel recuperare terre rare da varie fonti: minerali, scarti industriali (come fosfogesso o fanghi rossi) e materiali riciclati (catalizzatori esausti, batterie NiMH).
La Sfida: Capire i Segreti del Batterio Minatore
Abbiamo già fatto progressi! In passato, siamo riusciti a migliorare l’efficienza del bioleaching con G. oxydans identificando e modificando geneticamente alcuni geni coinvolti nella produzione di acido. Ad esempio, potenziando un enzima chiave (la glucosio deidrogenasi legata alla membrana, mgdh) e disattivando un sistema di trasporto del fosfato (pstS), abbiamo aumentato l’estrazione di terre rare da un minerale chiamato allanite fino al 73%. Fantastico, ma possiamo fare di meglio!
Il punto è che il bioleaching non è solo una questione di acidità (acidolisi). Si pensa che ci siano altri due meccanismi in gioco:
- Complessolisi: la creazione di complessi tra ioni metallici e composti organici prodotti dal batterio.
- Redoxolisi: reazioni che coinvolgono il trasferimento di elettroni.
Infatti, abbiamo notato che il biolisciviante prodotto da G. oxydans sembra più efficace dell’acido gluconico puro alla stessa acidità (pH). Questo suggerisce che ci siano altri “ingredienti segreti” nel cocktail microbico. Ma come trovarli? Gli screening basati solo sulla produzione di acido potrebbero non essere sufficienti. Dovevamo guardare direttamente all’efficienza di estrazione!
Il Nostro Piano: Uno Screening Diretto su Scala Genomica
Per affrontare questa sfida, abbiamo deciso di fare qualcosa di audace: uno screening diretto su scala genomica per identificare *tutti* i geni importanti per il bioleaching delle terre rare in G. oxydans B58.
Prima di tutto, abbiamo creato una nuova “collezione” di mutanti knockout dell’intero genoma. Immaginate una libreria dove ogni libro (gene non essenziale) ha una versione “difettosa” (knockout). La nostra nuova collezione, chiamata QC (Quality-Controlled), è super efficiente: abbiamo ridotto la ridondanza dell’85% rispetto alla migliore collezione precedente, passando da migliaia di mutanti a “solo” 2733, uno per quasi ogni gene non essenziale. Questo ci ha permesso di fare uno screening più mirato e meno costoso.
Poi, abbiamo sviluppato un test rapido in micropiastre. Abbiamo usato una polvere di monazite sintetica (la monazite è un minerale importante per le terre rare) contenente solo neodimio (Nd) e un colorante speciale, l’Arsenazo-III, che cambia colore (da rosa a blu) quando lega le terre rare disciolte. Mettendo ogni mutante della nostra collezione a contatto con la monazite e poi aggiungendo il colorante, potevamo vedere direttamente quali mutanti erano più o meno bravi a estrarre il neodimio in base all’intensità del colore blu.

Le Scoperte: Geni Sorprendenti e Meccanismi Nascosti
I risultati sono stati elettrizzanti! Abbiamo identificato ben 89 geni la cui interruzione influenzava significativamente l’estrazione di neodimio.
- 21 di questi erano già noti per essere coinvolti nella produzione di acido, confermando l’affidabilità del nostro test.
- Ma, cosa più importante, ben 68 geni erano completamente nuovi in questo contesto! Non erano mai stati associati prima al bioleaching.
Abbiamo selezionato 12 mutanti promettenti (alcuni che aumentavano molto l’estrazione, altri che la diminuivano) per esperimenti di validazione su scala di laboratorio, misurando l’estrazione con una tecnica super precisa (ICP-MS). I risultati hanno confermato le nostre scoperte:
- 8 mutanti hanno mostrato aumenti significativi nell’estrazione di neodimio, fino a un incredibile +111% rispetto al ceppo di controllo (il mutante δGO_1598, con interruzione del gene pyrE).
- Un mutante (δGO_1096, interruzione del gene typA) ha invece ridotto drasticamente l’estrazione del 97%.
Ma la scoperta forse più intrigante è stata un’altra: abbiamo misurato il pH del biolisciviante prodotto da questi 12 mutanti. Ebbene, 9 su 12 non hanno mostrato cambiamenti significativi di pH rispetto al controllo! Solo 3 lo hanno fatto, e in due casi la variazione era minima. Il mutante δGO_1096 (quello che riduceva l’estrazione) è stato l’unico ad aumentare significativamente il pH.
Cosa significa tutto questo? Significa che molti dei geni che abbiamo scoperto influenzano il bioleaching attraverso meccanismi diversi dalla semplice produzione di acido! È la prova che cercavamo: il cocktail di G. oxydans ha davvero degli assi nella manica oltre all’acidità.

Indagando sui Sospetti: Cosa Fanno Questi Geni?
Abbiamo analizzato le funzioni dei 68 nuovi geni scoperti. Molti sembrano coinvolti in processi cellulari fondamentali:
- Legame di ioni metallici e riparazione del DNA: Questi erano i gruppi funzionali più arricchiti. Forse l’interruzione di questi geni modifica indirettamente l’espressione di vie metaboliche che producono composti utili al bioleaching, o altera la risposta allo stress ossidativo generato durante il processo.
- Risposta allo stress: L’interruzione di geni come fpg (GO_1968) o cycD (GO_1991), coinvolti nella riparazione del DNA da stress ossidativo o nel bilancio redox, aumentava il bioleaching. Al contrario, l’interruzione di typA (GO_1096), anch’esso legato alla risposta allo stress, lo diminuiva drasticamente. Questo suggerisce un delicato equilibrio nella gestione dello stress cellulare.
- Regolazione genica: Geni che codificano per regolatori trascrizionali (come phoB, un dominio LysR, yafY, o una proteina HTH ipotetica GO_102) sono risultati importanti. La loro interruzione, che aumentava il bioleaching, potrebbe rimuovere dei “freni” metabolici.
- Metabolismo dei nucleotidi: L’interruzione di geni come pyrE (GO_1598, che ha dato l’aumento maggiore!), xdhC (GO_1113) o GO_2555 aumentava l’estrazione. Forse questo porta all’accumulo di intermedi metabolici che possono chelare i metalli (come l’orotato) o accelerare altre reazioni utili.
- Trasporto e membrana: L’interruzione di un gene per un trasportatore di membrana (GO_2946, forse legato alla sintesi di polisaccaridi) o di un recettore TonB (GO_19, legato all’assorbimento del ferro) migliorava il bioleaching, forse alterando la permeabilità cellulare o la percezione dei nutrienti.
È interessante notare che non abbiamo trovato prove evidenti di un singolo gene che codifica per una molecola redox specifica (come una flavina) o un chelante forte (come un sideroforo) la cui interruzione spieghi da sola l’aumento di efficacia. Molti dei geni identificati sembrano avere ruoli regolatori. Questo potrebbe significare che i meccanismi di complessolisi o redoxolisi, se presenti, sono controllati da più geni ridondanti, oppure che questi geni sono essenziali e difficili da identificare con questo approccio.
Mettere le Cose in Prospettiva e Guardare al Futuro
È importante sottolineare che, sebbene gli aumenti ottenuti con le singole interruzioni geniche siano notevoli (fino al 111%), non raggiungono ancora i livelli stratosferici ottenuti in precedenza combinando modifiche genetiche mirate (come la delezione di pstS e l’iperespressione di mgdh, che sullo stesso substrato di monazite hanno dato un aumento del 1186%!). Questo ci dice che probabilmente la strada per un bioleaching super-efficiente passa attraverso modifiche multiple e mirate, ispirate però dalle scoperte che stiamo facendo ora.
Abbiamo anche provato a ingegnerizzare il gene GO_1096: la sua iperespressione ha aumentato l’estrazione del 64% rispetto al ceppo selvatico, confermando il suo ruolo positivo. Curiosamente, la sua completa eliminazione (delezione pulita) non ha ridotto l’estrazione tanto quanto la sua interruzione parziale (transposone), suggerendo meccanismi compensatori o effetti collaterali dell’inserzione del transposone. La biologia è complessa!
Questo studio rappresenta, a nostra conoscenza, il primo screening diretto dell’intero genoma per il bioleaching di un metallo estratto. Ci ha permesso di spostare l’attenzione dal solo meccanismo dell’acidolisi e di identificare decine di nuovi geni che influenzano il processo, molti dei quali non alterano il pH. È una forte indicazione che il bioleaching di G. oxydans è un fenomeno più complesso e sfaccettato di quanto pensassimo, probabilmente basato su una sinergia tra acidità e altri composti prodotti dal batterio.
La nostra nuova collezione QC di mutanti è uno strumento prezioso per esplorare ulteriormente la funzione genica in G. oxydans. Le scoperte fatte aprono nuove strade per l’ingegneria genetica di questo microrganismo, con l’obiettivo di creare “super-batteri” capaci di estrarre terre rare in modo efficiente e sostenibile. C’è ancora molta strada da fare per capire appieno i meccanismi molecolari e per portare queste tecnologie su scala industriale, ma siamo convinti che il bioleaching abbia un potenziale enorme per contribuire a un futuro più verde. E noi siamo qui, in laboratorio, a cercare di svelare i segreti di questi incredibili batteri minatori!
Fonte: Springer







